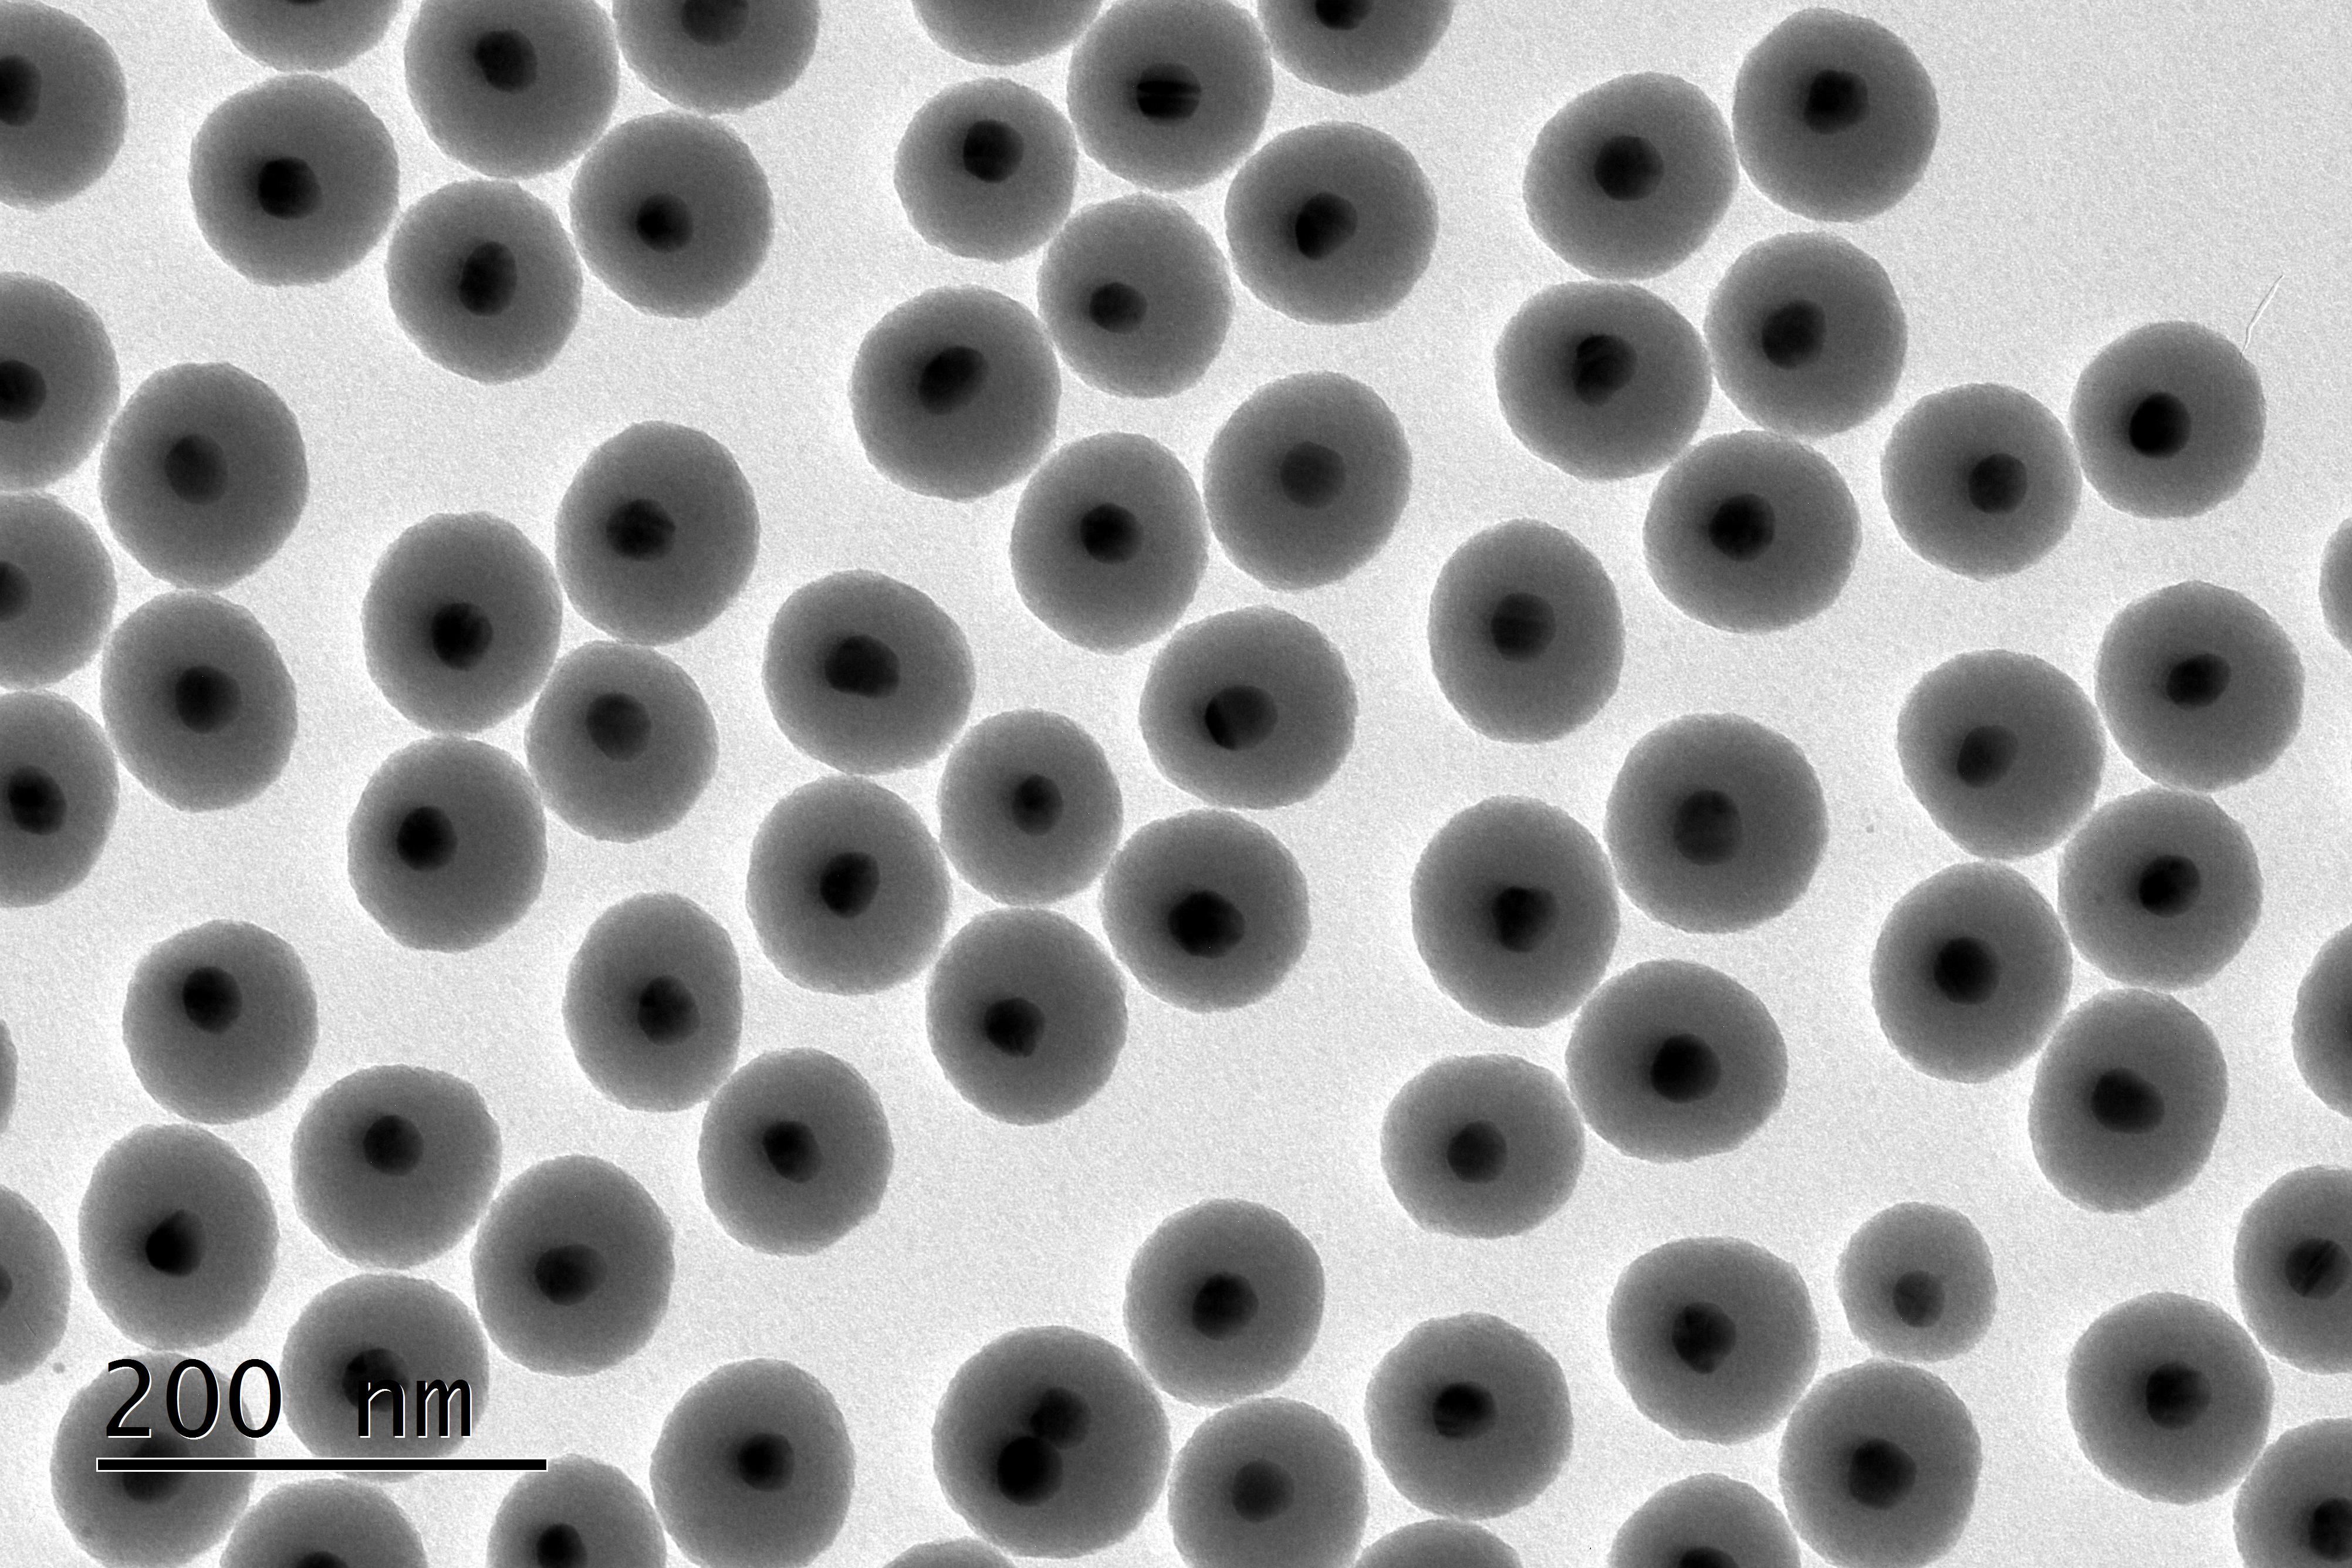

Adenosine-Monophosphate-Assisted Homogeneous Silica Coating of Silver Nanoparticles in High Yield
This study introduces a method for coating silver nanoparticles with silica via surface modification with adenosine monophosphate (AMP), enabling uniform shell formation with precise control over thickness and the potential for mesoporous coatings using CTAC as a template. Nanomaterials, 2023, 13(20), 2788
See more at : https://doi.org/10.3390/nano13202788
Tailoring Mesoporous Silica-Coated Silver Nanoparticles and Polyurethane-Doped Films for Enhanced Antimicrobial Applications
The rise of multidrug-resistant bacteria is a growing health concern, requiring new antibacterial solutions. This study focused on mesoporous silica-coated silver nanoparticles, demonstrating their strong antibacterial effects against both Gram-negative and Gram-positive bacteria, unlike inert gold nanoparticles. Smaller silver nanoparticles, when coated and surface-charged, showed enhanced antibacterial activity. Additionally, films doped with these nanoparticles exhibited improved antibacterial properties, highlighting their potential use in healthcare and food industries to combat resistant bacteria. Nanomaterials 2024, 14(5), 462
See more at: https://doi.org/10.3390/nano14050462
Synthesis of Mesoporous Silica Coated Gold Nanorods Loaded with Methylene Blue and Its Potentials in Antibacterial Applications
In this work, the successful preparation and characterization of gold nanorods (AuNRs) coated with a mesoporous silica shell (AuNRs@Simes) was achieved. Conjugation with methylene blue (MB) as a model drug using ultrasound-stimulated loading has been explored for further application in light-mediated antibacterial studies. Lyophilization of this conjugated nanosystem was analyzed using trehalose (TRH) as a cryogenic protector. The obtained stable dry formulation shows potent antimicrobial activity against Gram-negative (Escherichia coli) and Gram-positive (Staphylococcus aureus) bacteria after a simple post-treatment irradiation method with a red laser during a short time period. Nanomaterials, 2021, 11(5), 1338.
See more at: https://doi.org/10.3390/nano11051338
Exploring the Control in Antibacterial Activity of Silver Triangular Nanoplates by Surface Coating Modulation
In this study, silver triangular nanoplates (AgNTs) and their silica-coated composites were synthesized and characterized. Different surface coatings, including organic coatings like PVP (Polyvinylpyrrolidone) and MHA (16-mercaptohexadecanoic acid), and inorganic silica coatings (≈5 nm), were explored to modulate antibacterial effects. The antibacterial properties of these coatings were tested on Gram-positive and Gram-negative bacteria. The results showed that AgNTs with an organic MHA coating exhibited enhanced antimicrobial activity compared to traditional spherical silver colloids. In contrast, a thicker inorganic silica coating reduced, but did not eliminate, the antibacterial effects. Additionally, the surface charge of silica-coated AgNTs played a significant role in their effectiveness against S. aureus-ATCC 25923, with MIC/MBC values comparable to those of AgNTs with organic coatings. Frontiers in Chemistry: Nanoscience, 2019, 6, 2018.
See more at: https://doi.org/10.3389/fchem.2018.00677